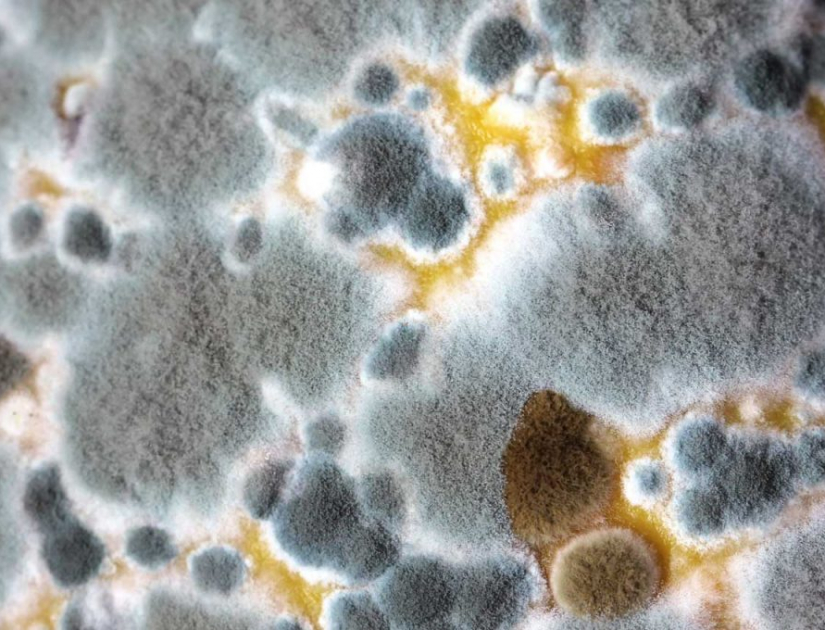

Pleśń – utajniony wróg
Czarna pleśń (black mold, mildew) jest najbardziej rozpowszechnionym rodzajem pleśni z jakim przychodzi się nam spotykać. Jednocześnie jest ona prawdopodobnie jednym z największych zagrożeń dla naszego „well being”. Grzybnia czarnej pleśni zwykle rośnie w miejscach ciepłych i wilgotnych o słabej wentylacji. Może to mieć miejsce zarówno wewnątrz domów jak i na zewnątrz. W naszym przypadku zainteresujemy się głównie tym co ”mieszka” w naszych domach.
Black mold występuje głównie w łazienkach, niewietrzonych piwnicach czy garażach. Czasami „przyozdabia” ściany, lub występuję schowana za wszelkiego rodzaju ściankami, listwami lub też w ciemnych pomieszczeniach. Grzybnia rosnąc wydziela charakterystyczny zapach często znany jako „stęchlizna”. W czasie wzrostu grzybnia wysyła miliony zarodników, które przenoszone z powietrzem stanowią zagrożenie dla naszego zdrowia. Szczególnie zagrożone działaniem pleśni są osoby starsze, kobiety w ciąży, dzieci oraz osoby cierpiące na choroby płuc (astma, chroniczne zapalenie oskrzeli), dla tych osób ekspozycja na pleśnie może okazać się fatalna.
Krótka ekspozycja na duże ilości sporów zwykle manifestuje się bólami głowy, żołądka czy wszelkiego rodzaju skurczami w przewodzie pokarmowym przebiegającymi z biegunką. Jeśli osoba wyeksponowana jest na działanie przez kilka dni objawy mogą się pogorszyć.
W wielu wypadkach nie jesteśmy wyeksponowani na działanie dużej ilości zarodników. Długotrwała ekspozycja na zarodniki black mold może spowodować powstanie objawów alergicznych przebiegających ze łzawieniem oczu, bólami głowy czy powstaniem obfitej wydzieliny z nosa. Czasami może pojawić się gorączka. Powyżej opisane objawy mogą występować także w wielu wirusowych zapaleniach górnych dróg oddechowych, dlatego postawienie dobrej diagnozy alergii na pleśnie może uchronić pacjenta przed przyjmowaniem wielu chemicznych leków używanych do leczenia zapaleń górnych dróg oddechwych. Osoby cierpiące na astmę oskrzelową, chroniczne zapalenie oskrzeli lub rozedmę (emphysema) uskarżają się na gwałtowne pogorszenie objawów po ekspozycji na zarodniki black mold.
U osób cierpiących na łuszczycę i wszelkiego rodzaju egzemy (zapalenie skóry) występuje gwałtowne pogorszenie objawów.
Systemem najbardzej wyeksponawanym, a także najczęściej atakowanym przez zarodniki pleśni jest nasz układ oddechowy. Jak już wspomnialem może dojść do nasilenia objawów astmy czy COPD. Długotrwała ekspozycja na zarodniki pleśni powoduje też powstanie stanów zapalnych w płucach niszczących tkankę i powodujące powstanie blizn wewnątrz tkanki płucnej. W niektórych przypadkach zarodniki grzyba dostając się do już powstałych zmian w płucach (np. jamy po grużlicze) mogą powodować wzrost grzybni wewnątrz płuc (Aspergiloma). Długotrwała ekspozycja na działanie grzybni może leżeć u podstaw niektórych chorób nowotworowych.
O ile objawy po działaniu pleśni mogą być różne i przypominać inne, o tyle sama diagnostyka jest raczej prosta. Istnieje szereg naturalnych terapii pozwalających usunąć zarodniki pleśni z naszego ciała i poprawić stan zdrowia. Aby rozpoznać czy dany pacjent miał kontakt z zarodnikami pleśni nie trzeba wykonywać bolesnych i niezbyt wygodnych testów skórnych. Można je zastąpić testami elektronicznymi pozwalającymi szybko i bezboleśnie stwierdzić ekspozycję na działanie pleśni. W przypadku pleśni leczymy nie tylko pacjenta. W wielu wypadkach konieczne jest także usunięcie pleśni z jego otoczenia.
Zabiegi są pokrywane przez większość planów medycznych.
Dr. Andrzej Salaniuk N.D.
Lakeshore Natural Health Clinic
2399 Cawthra Road #101, Mississauga. Tel: 416-830-0626
Serwisy pokryte przez większość ubezpieczeń/benefity.
Możliwość bezpośredniego rozliczania z kompaniami ubezpieczeniowymi. Gift certificates available.







Comment (0)